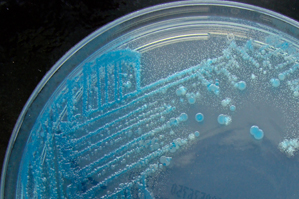

A simple solution for a big challenge
There are approximately 5 nonillion bacteria on earth (where a million has six zeros after the one, a nonillion has 30 zeroes). The microorganisms that live in the environment and in animal “microbiomes” (the collection of all the bacteria that call an animal home) represent the most diverse group of species around. They can be used to discover new antibiotics (some of them are very good at killing their neighbors) and identifying those in the human microbiome could lead to a much better understanding of many diseases like various cancers and metabolic syndromes.
But for unknown reasons, the vast majority of these little guys cannot be grown in the lab.
A few weeks ago I mentioned two professors who have figured out how to coax previously “uncultivable” bacteria into surviving on a petri dish. Kim Lewis and a post-doc in his lab have set up a non-profit called Sample America to put some of those techniques into action as they scour the nation for new antibiotics.
 Today I want to tell you about one technique in particular, which Slava Epstein’s team recently published in the journal Applied and Environmental Microbiology. “It is much simpler than it may appear,” he said. “It is remarkably simple: it involves cultivation in nature as opposed to the lab, cultivation of cells in their natural environment using the soup of natural growth factors as the medium…And that’s all.” That’s the kind of thing that makes
Today I want to tell you about one technique in particular, which Slava Epstein’s team recently published in the journal Applied and Environmental Microbiology. “It is much simpler than it may appear,” he said. “It is remarkably simple: it involves cultivation in nature as opposed to the lab, cultivation of cells in their natural environment using the soup of natural growth factors as the medium…And that’s all.” That’s the kind of thing that makes
Of course, he continued, we don’t know exactly what the soup contains; we don’ know which growth factors are critical for the cultivation of certain bacteria over others. “But who cares?” he said. All they’re trying to do for now is grow the suckers.
So, how do they do it? Also simple. They put a “petri dish” with permeable membranes (like the one above) into the native environment of the bacteria they’re trying to grow and let them hang out with their friends and family, just separated a little…Kind of like the boy in the bubble.
Several (or several hundred, your choice) mini petri dishes so designed can be fashioned into a little multiwell plate like the one to the right. By adding a solution  of various bacteria of known concentration to the plate, you can ensure that only one cell makes it into each of the wells. This means you have many more opportunities for success. Some bacteria cultivated will have already been identified and are easily grown in the lab, but others could be new species or even representative of an entirely unknown species group.
of various bacteria of known concentration to the plate, you can ensure that only one cell makes it into each of the wells. This means you have many more opportunities for success. Some bacteria cultivated will have already been identified and are easily grown in the lab, but others could be new species or even representative of an entirely unknown species group.
First the team did this in the environment, placing little multiwell petri dish plates under a rock in the ocean or on land. But the most recent paper describes the first use of this approach to study bacteria in the human body. Specifically, they grew bacteria inside someone’s mouth.
Now, I never wore my retainer as a kid and therefore I ended up with braces. Twice. But if I knew that my retainer was contributing to science, I may have thought differently about it. The folks at Forsyth rigged up a retainer for one human subject that had one of these plates embedded on the plastic part that meets the roof of the mouth.
These two methods (single-cell and multi-cell approaches) along with a standard bacterial cultivation approach yielded a total of 10 species that had only previously been seen as a molecular signature and 20 species that had not previously been cultivated in the lab.
The team is sequencing the genomes of 27 of these newbies, five of which have already been released.
Cover photo: Nathan Reading, “ChromID Salmonella Agar – negative sample” September 12, 2011 via Flickr. Creative Commons Attribution.





